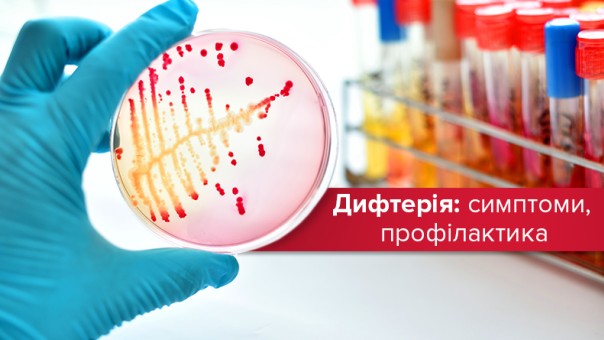

У всей семьи - дифтерия
Эту крайне опасную болезнь обнаружили в Крапивном Нежинского района — сначала у 11-летнего Ярослава Божка, а затем и у его сестрички, братика, матери и отчима. Все они сейчас в разных больницах, а в селе работает санэпидемслужба области и района.
Ярослав — четвертый в Украине, кто в этом году подхватил дифтерию. С начала 2018-го 1 случай был зафиксирован в Киевской области и 2 — в Луганской.
Заместитель главного врача Черниговской областной детской больницы и главный внештатный; педиатр области Людмила Кривей рассказывает:
- Мальчик заболел 8 июля: у него повысилась температура, появились боли в горле, За медицинской помощью родители не обратились, пытались сбить температуру жаропонижающими средствами. Вызвали медиков только в пятницу, 13-го, когда ребенку стало хуже.
- Мать, Татьяна Божок, позвонила мне с жалобой, что у сына рвота и понос. Я сказал срочно вызвать «скорую». — говорит фельдшер крапивненского фельдшерского пункта Сергей Бережняк.
Ярослава госпитализировали в Нежинскую центральную районную больницу.
— Медработники сразу заподозрили дифтерию. Ребенка интубировали (ввели в гортань специальную трубку для облегчения дыхания. — Авт.), начали вводить антибиотики, проводить инфузионную терапию (ставить капельницы — Авт.) и вызвали реанимационную бригаду из нашей больницы, — продолжает Людмила Ивановна. — Бригада приехала в Нежин с дифтерийным антитоксином и там же ввела его ребенку. Состояние мальчика стабилизировали и в 23.15 перевезли его в наше реанимационное отделение.
Взятые мазки лабораторно подтвердили токсичную форму дифтерии. В Крапивном начали выявлять и обследовать всех, с кем общался Ярослав. — так называемых контактных лиц. У младших детей из этой семьи была несколько повышенная температура (37.2 градуса) и немного покрасневшее горло. Их также забрали в районную больницу, потом перевели в областную. Сейчас 5-летняя Марина и 3-летний Денис с мамой лежат в инфекционном отделении ЧОДБ, им также ввели противодифтерийную сыворотку.
- Самый старший мальчик недостаточно вакцинирован - с нарушением графика. Это, а также позднее обращение повлекло сложное протекание болезни. Он получает необходимое лечение, однако до сих пор в тяжелом состоянии, на искусственной вентиляции легких, — комментирует Людмила Кривец. — Младший братик тоже привит недостаточно, но его своевременно начали лечить. Девочка вакцинирована согласно графику, поэтому у нее, кроме повышения температуры и незначительных изменений в горле, других признаков болезни нет. У обоих младших детей состояние средней степени тяжести. Поскольку это очень серьезная болезнь, у детей строгий постельный режим, их постоянно осматривает кардиолог, делаются кардиограммы.
Дифтерия также лабораторно подтверждена у матери и ее гражданского мужа и отца младших детей Ивана Бенчака. Он сейчас в Нежинской райбольнице.
За 30-летнюю практику Сергей Бережняк с дифтерией встретился впервые. А вот его коллега из соседнего села Нежинское (бывшая Григоро-Ивановка) Татьяна Орел е этим заболеванием сталкивалась.
- Году наверное, в 2005-м болела моя односельчанка. Лечилась в Нежине, это был не очень тяжелый случай, без последствий для женщины.
Во время эпидемии дифтерии в Украине с 1991 по1998 год, вызванной низким охватом детей вакцинацией и отсутствием ревакцинации взрослых, заболело около 20 тысяч человек, 696 из них скончались. В последние годы регистрировались единичные случаи: 2011 - 8,2012 - 5,2013 - 6,2014 - 4, 2015 - 2, 2016 — 4. Слава богу, никто не умер. В 2017-м дифтерию вообще не фиксировали.
Впрочем, недавно эпидемиологи предупреждали, что вслед за эпидемией кори в Украину придет дифтерия. И все это из-за низкого уровня вакцинации, в результате чего не вырабатывается коллективный иммунитет.
- Случай кропивненской семьи лишний раз доказывает, что вакцинироваться нужно обязательно! — подчеркивает Людмила Кривец. — Вот девочка правильно привита| и у нее, в отличие от брата, не токсичная форма дифтерии. Ватин как для детей, так и для взрослых у нас дортаточно.
Вакцины чисто против дифтерии нет, есть комплексная — адсорбированная коклюшно-дифтерийно-столбнячная (АКДС). Проблема в том, что она индийского производства, доверия к ней нет. Татьяна Орел говорит:
- Люди не только в нашем, но и в других селах отказываются от прививки детей именно индийской вакциной, так как она тяжело переносится: дети страдают от высокой (до 39 градусов) температуры, не становятся на ножку (если укол делается в бедро). В отказах так и пишут, что если бы вакцина была другого производителя, согласились бы. Но вакцинироваться все равно надо. Это не стопроцентная страховка от заболевания, однако в случае заражения оно будет переноситься намного легче.
Алина Ковалева, "ГАРТ" №29 (2885) от 19 июля 2018
Хочете отримувати головне в месенджер? Підписуйтеся на наш
Telegram.
Теги: дифтерия, Алина Ковалева, "ГАРТ"









